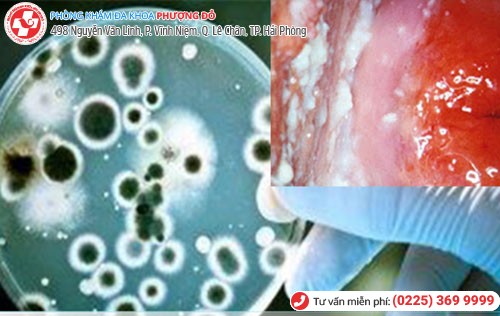
Nấm vùng kín do nhiều nguyên nhân gây nên Nấm vùng kín do nhiều nguyên nhân gây nên

Nấm phụ khoa có lẽ là nỗi ám ảnh của bất kỳ chị em phụ nữ nào, xuất phát từ nhiều nguyên nhân khác nhau, trong đó nấm Candida Albicans chiếm hơn 80% tỷ lệ mắc bệnh. Loại nấm ký sinh trên da và niêm mạc âm đạo này thường do sự mất cân bằng độ pH âm đạo khiến các tế bào nấm sinh sôi, phát triển và gây ngứa ngáy, kích ứng, sưng tấy vùng kín dữ dội.
Nhận biết chính xác nấm phụ khoa
Mùi, cảm giác ngứa ngáy, khó chịu xuất phát từ vùng kín do nấm không chỉ khiến chị em khó chịu, ảnh hưởng đến sinh hoạt và chất lượng đời sống tình dục. Nhận biết sớm các triệu chứng nấm phụ khoa là điều cần thiết.

Nấm phụ khoa khiến chị em ngứa ngáy vùng kín
- Vùng kín ngứa ngáy, khó chịu: Tùy theo mức độ bệnh cơn ngứa có thể âm ỉ hoặc dữ dội, lan nhanh đến môi lớn, môi bé, khắp vùng kín khiến chị em muốn gãi và rất khó chịu.
- Sưng tấy niêm mạc âm hộ, âm đạo: Xuất hiện những nốt mụn mẩn đỏ, vùng kín sưng tấy, niêm mạc âm đạo bị tổn thương nên dễ bị đau đớn, xót rát khi đi tiểu hoặc quan hệ tình dục.
- Khí hư ra nhiều: Viêm nhiễm phụ khoa khiến khí hư của chị em ra nhiều, có mùi hôi tanh khó chịu, màu trắng đục giống như bã đậu, đóng thành từng mảng ở âm hộ, âm đạo.
- Quan hệ tình dục đau rát: Do niêm mạc âm đạo bị tổn thương nên khi quan hệ tình dục chị em sẽ phải chịu những cơn đau đớn dữ dội, không đạt được khoái cảm, sự hưng phấn. Nếu giao hợp mạnh bạo có thể gây trầy xước và chảy máu.
Chị em có những dấu hiệu nấm phụ khoa nào? Miêu tả ngay với bác sĩ chuyên khoa TẠI ĐÂY để xác định được mức độ biểu hiện của bệnh và có hướng can thiệp kịp thời.
Nguyên nhân nấm phụ khoa
Vậy đâu là nguyên nhân nấm phụ khoa ở chị em phụ nữ có xu hướng ngày càng gia tăng?
Nấm vùng kín do nhiều nguyên nhân gây nên
✽ Mất cân bằng độ pH âm đạo: Nhất là khi chị em bị mệt mỏi, căng thẳng, mang thai… khiến hàm lượng nội tiết tố mất cân bằng, nấm men, vi khuẩn có hại dễ dàng xâm nhập, phát triển và gây bệnh.
✽ Vệ sinh vùng kín không sạch: Nhất là trước, sau khi quan hệ, trong chu kỳ kinh nguyệt, thụt rửa âm đạo quá sâu, sử dụng dung dịch vệ sinh có chứa nồng độ mạnh làm mất cân bằng pH âm đạo.
✽ Quan hệ tình dục không an toàn: Nấm men, nhất là nấm Candida dễ dàng lây nhiễm nếu giao hợp không sử dụng các phương pháp bảo vệ an toàn. Trường hợp quan hệ mạnh bạo sẽ khiến niêm mạc âm đạo tổn thương gây đau đớn, khó chịu.
✽ Đồ lót quá chật: Thói quen này là nguyên nhân khiến vùng kín bị ẩm ướt, bí bách, khó chịu, nóng rát nên tạo điều kiện thuận lợi cho vi khuẩn, nấm men có hại phát triển. Trường hợp sử dụng chung đồ lót, khăn tắm cũng có thể chị em bị nhiễm nấm phụ khoa.
✽ Ảnh hưởng của bệnh lý: Nhiễm nấm phụ khoa cũng dễ rơi vào các trường hợp sử dụng thuốc kháng sinh trong thời gian dài, hệ miễn dịch suy giảm, mắc bệnh đái tháo đường…
Nấm phụ khoa ở mức độ nào cũng khiến chị em luôn mệt mỏi, khó chịu, suy giảm chất lượng đời sống tình dục, ảnh hưởng đến chất lượng tinh trùng, dễ mắc nhiều bệnh viêm nhiễm phụ khoa khác, tăng nguy cơ vô sinh hiếm muộn. Do đó, tìm ra đúng nguyên nhân nhiễm nấm sẽ giúp giảm nguy cơ mắc bệnh, phòng tránh được hiệu quả nhất.
Phương pháp chữa nấm phụ khoa hiệu quả tại Phòng Khám Phượng Đỏ
Các bác sĩ chuyên khoa Phòng Khám Phượng Đỏ nhấn mạnh, vì viêm nhiễm nấm phụ khoa xảy ra ở vùng kín rất nhạy cảm, dễ tổn thương, vì vậy việc áp dụng các phương pháp tiên tiến sẽ rất quan trọng.

Nhiều ca nấm vùng kín được Phòng Khám Phượng Đỏ chữa trị thành công
Nhiều trường hợp bị viêm nhiễm do nấm phụ khoa được Phòng Khám Phượng Đỏ chữa trị hiệu quả nhờ phương pháp Oxygen O3 tiên tiến. Đây là phác đồ tối ưu được các chuyên gia khuyên dùng vì khắc phục hiệu quả những nhược điểm phương pháp truyền thống.
Chữa nấm phụ khoa bằng công nghệ Oxygen O3 dựa trên nguyên lý sử dụng oxy xanh cực mạnh để tác động trực tiếp lên vùng tổn thương nhằm tiêu diệt nấm men, vi khuẩn nhanh chóng, hiệu quả.
ƯU ĐIỂM PHƯƠNG PHÁP:
☑ Hiệu quả chữa bệnh lên đến 98%, đảm bảo tính an toàn.
☑ Thời gian hỗ trợ điều trị bệnh ngắn, chỉ 15-20 phút/ liệu trình.
☑ Đảm bảo chức năng sinh lý của vùng kín, không ảnh hưởng đến sinh sản.
☑ Tính thẩm mỹ vùng kín được đảm bảo, không gây đau đớn, không để lại sẹo.
☑ Kết hợp hiệu quả các phương pháp khác, ngăn ngừa nguy cơ bệnh tái phát đến mức tối đa.
Bên cạnh đó Phòng Khám Phượng Đỏ còn đảm bảo được các yếu tố về đội ngũ y bác sĩ, trang thiết bị y tế hiện đại, dịch vụ y tế chuyên nghiệp, đặt lịch khám dễ dàng với nhiều ưu đãi.
Hàng ngàn chị em phụ nữ thoát khỏi nỗi ám ảnh mang tên nấm phụ khoa. Bạn sẽ là người tiếp theo?
Chi phí chữa nấm phụ khoa bao nhiêu? Liên hệ ngay hotline 0225 369 9999 để được tư vấn miễn phí